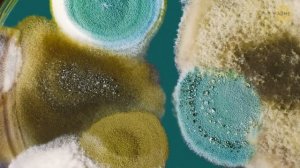
Куда исчез астероид после того, как уничтожил динозавров?

19:13
19:13
2026-03-17 12:16

 19:18
19:18
19:18
19:18
2026-03-17 14:00

 23:04
23:04

 23:04
23:04
2025-06-25 13:15

 2:54:48
2:54:48

 2:54:48
2:54:48
2026-03-16 14:00

 5:28
5:28

 5:28
5:28
2026-03-16 18:27

 9:37
9:37

 9:37
9:37
2026-03-15 10:33

 19:56
19:56

 19:56
19:56
2026-03-17 15:29

 12:08
12:08

 12:08
12:08
2026-02-27 12:31

 25:20
25:20

 25:20
25:20
2026-03-17 17:16

 2:17:46
2:17:46

 2:17:46
2:17:46
2026-03-15 23:40

 1:56:22
1:56:22

 1:56:22
1:56:22
2026-03-15 21:00

 11:03:06
11:03:06

 11:03:06
11:03:06
2025-10-20 06:19

 2:41:09
2:41:09

 2:41:09
2:41:09
2025-11-14 18:15

 2:42:49
2:42:49

 2:42:49
2:42:49
2024-01-30 15:40

 2:07:59
2:07:59

 2:07:59
2:07:59
2026-02-18 21:10

 11:52:60
11:52:60

 11:52:60
11:52:60
2025-01-24 09:38

 3:01:48
3:01:48

 3:01:48
3:01:48
2024-02-09 03:39

 2:17:40
2:17:40
![Alexia - Două Linii (Official Video 2026)]() 2:38
2:38
![Инна Вальтер - Мы друг другу никто (Премьера клипа 2026)]() 3:37
3:37
![Айна Гетегазова - Царь зверей (Премьера клипа 2026)]() 3:44
3:44
![Cvetocek7 - Проблема (Премьера клипа 2026)]() 2:29
2:29
![Жалолиддин Ахмадалиев - Ёлгон дунё (Премьера клипа 2026)]() 3:44
3:44
![NITI DILA - Запели капели (Премьера 2026)]() 2:14
2:14
![EDGAR - Букет из розовых тюльпанов (Премьера клипа 2026)]() 3:50
3:50
![Игорь Балан - Бывшая (Премьера клипа 2026)]() 3:44
3:44
![Рейсан Магомедкеримов - Баловала (Премьера клипа 2026)]() 3:27
3:27
![Хилола Хамидова - Хафа-Хафа (Премьера клипа 2026)]() 4:32
4:32
![Кирилл Туриченко - Королева любви (Премьера клипа 2026)]() 2:46
2:46
![Фати Царикаева - Ревность (Премьера клипа 2026)]() 3:27
3:27
![SVETLAYA - А и я (Премьера 2026)]() 2:18
2:18
![С 8 Марта, милые, красивые женщины]() 5:01
5:01
![Аюбхон Усмонов - Асал (Премьера клипа 2026)]() 3:28
3:28
![ARTEE - Ну и пусть (Премьера клипа 2026)]() 4:12
4:12
![Muboriz Usmonov ft. Hasanov - Be Tu (Official Video 2026)]() 3:09
3:09
![CHEPIKK - 5 минут назад (Премьера 2026)]() 3:09
3:09
![Алишер Абдугофуров - Кизимиз (Премьера клипа 2026)]() 4:20
4:20
![БАХТАВАР - RAMADAN (Премьера клипа 2026)]() 3:15
3:15
![Грандиозная подделка | Il falsario (2025)]() 1:55:41
1:55:41
![Игра со смертью | Play Dead (2025)]() 1:12:23
1:12:23
![Лакомый кусок | The Rip (2025)]() 1:52:50
1:52:50
![Военная машина | War Machine (2026)]() 1:49:24
1:49:24
![Тепло наших тел | Warm Bodies (2013)]() 1:37:49
1:37:49
![Точка замерзания | Dead of Winter (2025)]() 1:37:45
1:37:45
![Побег из плена | Prisoner of War (2025)]() 1:52:58
1:52:58
![Крипер | Keeper (2025)]() 1:38:41
1:38:41
![Охотник и охотница | Hunting Grounds (2025)]() 1:29:24
1:29:24
![Zомбилэнд: Контрольный выстрел | Zombieland: Double Tap (2019)]() 1:39:05
1:39:05
![Спрингстин. Избавь меня от небытия | Springsteen: Deliver Me from Nowhere (2025)]() 1:59:36
1:59:36
![Лило и Стич | Lilo & Stitch (2025)]() 1:49:28
1:49:28
![Тихое место: День первый | A Quiet Place: Day One (2024)]() 1:39:30
1:39:30
![Пункт назначения: Узы крови | Final Destination: Bloodlines (2025)]() 1:49:52
1:49:52
![Элементарно | Elemental (2023)]() 1:41:31
1:41:31
![Удачи, веселья, не сдохни | Good Luck, Have Fun, Don't Die (2025)]() 2:14:31
2:14:31
![Миссия невыполнима: Смертельная расплата | Mission: Impossible - Dead Reckoning (2023)]() 2:46:48
2:46:48
![Дикий робот | The Wild Robot (2024)]() 1:41:50
1:41:50
![Давид | David (2025)]() 1:49:18
1:49:18
![Носферату | Nosferatu (2024)]() 2:12:40
2:12:40
![Псэмми. Пять детей и волшебство Сезон 1]() 12:17
12:17
![Поймай Тинипин! Королевство эмоций]() 12:24
12:24
![Лудлвилль]() 7:05
7:05
![Команда Дино. Исследователи Сезон 2]() 13:26
13:26
![Монсики]() 6:30
6:30
![Ну, погоди! Каникулы]() 7:04
7:04
![Сборники «Зебра в клеточку»]() 45:30
45:30
![Простоквашино]() 6:30
6:30
![Зомби Дамб]() 5:14
5:14
![Корги по имени Моко. Новый питомец]() 3:28
3:28
![Синдбад и семь галактик Сезон 1]() 10:23
10:23
![Пластилинки]() 25:31
25:31
![Сборники «Простоквашино»]() 1:05:50
1:05:50
![Школьный автобус Гордон]() 12:34
12:34
![Тёплая анимация | Новая авторская анимация Союзмультфильма]() 10:46
10:46
![Команда Дино Сезон 2]() 12:31
12:31
![Кадеты Баданаму Сезон 1]() 11:50
11:50
![Отряд А. Игрушки-спасатели]() 13:06
13:06
![Сборники «Приключения Пети и Волка»]() 1:28:31
1:28:31
![Врумиз. 1 сезон]() 13:10
13:10
![Рыцарь семи королевств. Все серии]() 3:28:06
3:28:06
![Франкенштейн | Frankenstein (2025)]() 2:32:29
2:32:29
![Мир в огне (все серии) 4K]() 12:26:36
12:26:36
![СваТы 1 сезон(все серии)]() 2:17:36
2:17:36
![Сборник Синий Трактор]() 57:36
57:36
![Ми–Ми–Мишки 💫 Звездная история 🙃 Все серии ✨ Мультики для детей]() 2:10:31
2:10:31
![Дьявол носит Prada | The Devil Wears Prada (2006)]() 1:49:29
1:49:29
![Премьера: Предательство - фильм Андрея Медведева от 01.02.2026]() 59:17
59:17
![Лунтик | Танцы 💃💃💃 Сборник мультиков для детей]() 46:30
46:30
![КЛИПЫ 80-90 х - ЗОЛОТЫЕ ХИТЫ - ЛЮБИМЫЕ ПЕСНИ]() 2:07:05
2:07:05
![Максим ФАДЕЕВ feat. Григорий ЛЕПС - Орлы или вороны ft.и]() 4:38
4:38
![MAUR - Полетела (Премьера клипа 2025)]() 2:53
2:53
![Штрафбат(1-11 серии) HD 2004]() 8:05:56
8:05:56
![Три Кота | Сборник замечательных серий | Мультфильмы для детей😃]() 1:03:03
1:03:03
![Зверополис | Zootopia (2016)]() 1:48:48
1:48:48
![Барбоскины 1-30]() 2:21:36
2:21:36
![ХИТЫ 2025 ТАНЦЕВАЛЬНАЯ МУЗЫКА СБОРНИК]() 1:41:18
1:41:18
![Bakhtin - Целовала (Премьера клипа 2023)]() 3:16
3:16
![ЛУЧШИЕ ВИДЕО КЛИПЫ 80-90-х. Звёзды Эстрады. Золотые хиты. Супердискотека.]() 2:56:03
2:56:03
![Форсаж 9 | F9 (2021)]() 2:22:56
2:22:56

 2:17:40
2:17:40Скачать Видео с Рутуба / RuTube
| 256x144 | ||
| 426x240 | ||
| 640x360 | ||
| 854x480 | ||
| 1280x720 | ||
| 1920x1080 |
 2:38
2:38
2026-02-20 10:00
 3:37
3:37
2026-03-13 12:11
 3:44
3:44
2026-03-04 10:27
 2:29
2:29
2026-03-03 12:53
 3:44
3:44
2026-02-22 22:48
 2:14
2:14
2026-03-13 12:04
 3:50
3:50
2026-03-06 13:17
 3:44
3:44
2026-03-03 12:20
 3:27
3:27
2026-03-13 10:56
 4:32
4:32
2026-03-14 12:16
 2:46
2:46
2026-03-09 10:49
 3:27
3:27
2026-03-11 11:23
 2:18
2:18
2026-03-14 12:02
 5:01
5:01
2026-03-08 09:55
 3:28
3:28
2026-02-25 09:33
 4:12
4:12
2026-03-04 10:34
 3:09
3:09
2026-03-14 15:24
 3:09
3:09
2026-03-14 14:36
 4:20
4:20
2026-02-25 09:40
 3:15
3:15
2026-02-21 14:07
0/0
 1:55:41
1:55:41
2026-02-26 14:41
 1:12:23
1:12:23
2026-03-06 18:16
 1:52:50
1:52:50
2026-02-04 10:11
 1:49:24
1:49:24
2026-03-10 12:44
 1:37:49
1:37:49
2026-02-16 08:53
 1:37:45
1:37:45
2026-01-26 14:35
 1:52:58
1:52:58
2026-01-26 14:34
 1:38:41
1:38:41
2026-03-06 19:13
 1:29:24
1:29:24
2026-02-06 18:40
 1:39:05
1:39:05
2026-02-16 01:07
 1:59:36
1:59:36
2026-02-13 14:02
 1:49:28
1:49:28
2026-01-23 18:44
 1:39:30
1:39:30
2026-01-23 18:43
 1:49:52
1:49:52
2026-01-23 18:44
 1:41:31
1:41:31
2026-01-23 18:43
 2:14:31
2:14:31
2026-03-12 23:32
 2:46:48
2:46:48
2026-01-23 18:43
 1:41:50
1:41:50
2026-01-23 18:44
 1:49:18
1:49:18
2026-01-29 11:25
 2:12:40
2:12:40
2026-01-23 18:44
0/0
2021-09-22 22:23
 12:24
12:24
2024-11-27 13:24
 7:05
7:05
2025-12-30 20:49
2021-09-22 22:54
 6:30
6:30
2022-03-29 19:16
 7:04
7:04
2026-01-12 15:05
 45:30
45:30
2025-12-11 18:53
 6:30
6:30
2022-03-30 13:57
 5:14
5:14
2024-11-28 13:12
 3:28
3:28
2025-01-09 17:01
2021-09-22 23:09
 25:31
25:31
2022-04-01 14:30
 1:05:50
1:05:50
2026-03-05 14:34
 12:34
12:34
2024-12-02 14:42
 10:46
10:46
2022-06-07 11:02
2021-09-22 22:40
2021-09-22 21:17
 13:06
13:06
2024-11-28 16:30
 1:28:31
1:28:31
2026-03-05 13:25
2021-09-24 16:00
0/0
Скачать популярное видео
Популярное видео
 3:28:06
3:28:06
2026-02-24 11:12
 2:32:29
2:32:29
2025-11-17 11:22
 12:26:36
12:26:36
2025-11-14 19:42
 2:17:36
2:17:36
2025-07-24 20:55
2024-11-13 13:06
2024-01-17 17:34
 1:49:29
1:49:29
2023-04-27 15:40
 59:17
59:17
2026-02-01 14:02
2024-08-05 22:22
2023-05-31 14:59
 4:38
4:38
2017-12-19 08:20
 2:53
2:53
2025-04-24 09:53
 8:05:56
8:05:56
2017-07-08 19:33
 1:03:03
1:03:03
2026-02-02 23:42
 1:48:48
1:48:48
2024-12-16 19:01
2024-12-16 20:15
2024-06-25 00:21
 3:16
3:16
2023-10-13 14:26
 2:56:03
2:56:03
2021-03-15 02:49
 2:22:56
2:22:56
2023-04-25 23:06
0/0

